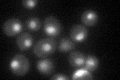
YML112W
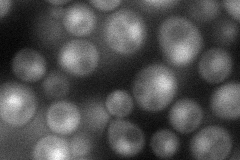
YML112W
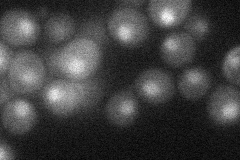
YML112W
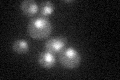
YML112W
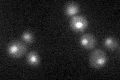
YML112W

View description
Gamma subunit of C-terminal domain kinase I (CTDK-I), which phosphorylates both RNA pol II subunit Rpo21p to affect transcription and pre-mRNA 3' end processing, and ribosomal protein Rps2p to increase translational fidelity
Localization:
Intensity:
Fold change:
Significance:
-
C’ GFP library in SD
nucleus32.73 -
N' NOP1pr-GFP in SD
cytosol,nucleus67.3989 -
N' TEF2pr-mCherry in SD
nucleus19.5096 -
N' NATIVEpr-GFP in SD

punctate24.4784 -
N' TEF2pr-VC and Cyto-VN in SD

#N/A0 -
C’ GFP library in SD+DTT

nucleus35.171.07No -
C’ GFP library in SD+H2O2
nucleus33.111.01No -
C’ GFP library in Starvation Media
nucleus280.85No -
C’ GFP library on the background of Pup2-DaMP

nucleus -
C’ GFP library on the background of CCT mutant

nucleus36.17841.10507No
